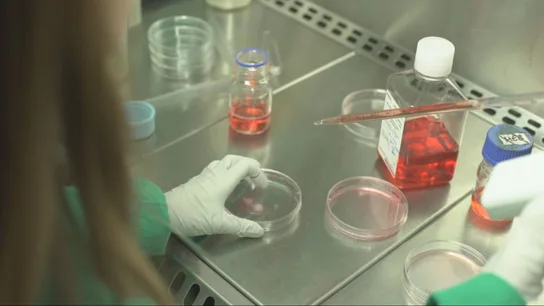

Problema de la vivienda
Periodista de laSexta Noticias en la delegación de Andalucía.

Problema de la vivienda

Pide toda la información al respecto

Las cifras le contradicen

Una publicación paralizada

De borrasca en borrasca

Es posible

42 años de prisión

En Sevilla

Una noche aguantando el aliento

San Enrique, Guadiaro y Sotogrande
En el Hospital de Jerez de la Frontera

Conflicto laboral y ambiental

Valorado en unos 8.000 euros

Convenio sin actualizar desde 2008

Coloca pegatinas en los cristales

¿Son apropiados?

¿Quién hereda?

Motores en las piernas